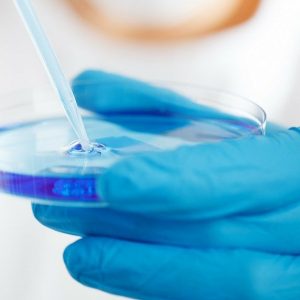
blue gloved person holding a petri dish

Studies Confirm, Harm From GMO Foods Is Real – Here Is How to Avoid Them
Wendy Miller via NaturalHealth365 – When the concept of genetically modified foods was first discussed, the intent was positive. Because, according to some scientists, GMO technology was supposed to help farmers…
Study: Adding Color to Your Plate May Lower Risk of Cognitive Decline
American Academy of Neurology (AAN) via Newswise – A new study shows that people who eat a diet that includes at least half a serving per day of foods high in…
Radio-Wave Therapy Is Safe for Liver Cancer Patients and Shows Improvement in Overall Survival
Wake Forest Baptist Medical Center via EurekAlert – Researchers at Wake Forest School of Medicine have shown that a targeted therapy using non-thermal radio waves is safe to use in the treatment of…
Novel Therapeutic Agent Could Be Effective for Treating Cancers With Certain Gene Mutations
Mount Sinai Health System via News-Medical – Mount Sinai researchers have developed a therapeutic agent that shows high effectiveness in vitro at disrupting a biological pathway that helps cancer survive, according…
Discover the Cancer-Fighting Benefits of Beet Juice
Abby Campbell via NaturalHealth365 – Did you know that the benefits of beet juice include fighting cancer? In fact, beetroots have been used as a treatment for cancer in Europe for…
Does Histamine Intolerance Cause Allergies, Headaches & Bloating?
Dr. Josh Axe, DC, DNM, CN – To alleviate allergy-like symptoms, many people seek natural remedies for allergies — yet some folks continue to experience difficult, even strange, symptoms. Frustrating! Until recently, most health…
Eating Organic Helps Kids Score Higher on Cognitive Tests, According to Study
Stephanie Woods via NaturalHealth365 – Have you ever noticed that you have more energy when you eat nutrient-rich, organic food and have a better overall feeling of wellness than when…
Metabolic Syndrome Linked to Increased Risk of Second Stroke, Death
American Academy of Neurology (AAN) via Newswise – People with larger waistlines, high blood pressure and other risk factors that make up metabolic syndrome may be at higher risk for having…
SHOCKING Truth You Should Know About Your Drinking Water
Wendy Miller via NaturalHealth365 – Too many people believe that since our drinking water is readily available and clear, it contains few to no contaminants. The fact is, almost 41% of…
Healing Trauma: Research Links PTSD, Emotion Regulation and Quality of Life
Binghamton University via EurekAlert – We often talk about the coronavirus pandemic in terms of health or economic impacts: the numbers of cases and deaths, the persistence of long-haul COVID, lost…
Excessive Body Fat Can Increase the Risk of Dementia
University of South Australia via News-Medical – It’s the global epidemic that affects two in every five adults, but as obesity continues to expand waistlines worldwide, researchers at the University of…
Always Have A Bloated Stomach? Here Are 10 Reasons Why
Jillian Levy, CHHC via Dr. Axe – Stomach bloating is so common these days that it’s been called an “epidemic.” If you frequently deal with distention, digestive discomfort and a bloated…
Pain-Fighting Quinoa Breakfast Porridge
Dr. Don Colbert – This easy-to-make and filling quinoa breakfast porridge offers blood-sugar stabilizing protein, anti-inflammatory properties, and tons of antioxidants to help fight pain. Ingredients: 2 cups cooked quinoa 1…
UCSF Researchers Discover How the Immune System May Play a Role in Miscarriage
University of California – San Francisco via News-Medical – Researchers at UC San Francisco are zeroing in on how the immune system may play a role in miscarriage, which affects about…